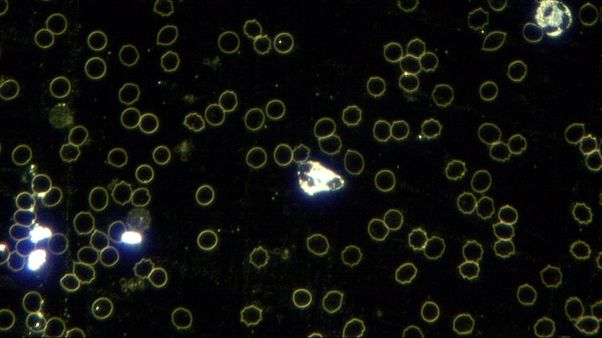

Vital Vibes has been using frequencies to assist and support healing since 2003. We combine natural herbs with frequency based equipment to assist people to heal. During the pandemic of 2020 and 2021, we have helped many to recover from the condition at hand.
 In 2021, Felicity Hume and I joined forces to create a formula to support, restore and assist the immune system. Initially, this formula, was to support those that had contracted the virus. This grew into supporting those that wanted to protect themselves too. At that time, reports started emerging about injuries from pharmaceuticals used against the virus and we felt a deep need to support these people. After many hours of constant research, sourcing and obtaining the highest quality ingredients (both locally and internationally), and constant upgrades (as new research was found), we created the energetic formula. We are proud to introduce you to the Immune Restore Plasma Remedy.
In 2021, Felicity Hume and I joined forces to create a formula to support, restore and assist the immune system. Initially, this formula, was to support those that had contracted the virus. This grew into supporting those that wanted to protect themselves too. At that time, reports started emerging about injuries from pharmaceuticals used against the virus and we felt a deep need to support these people. After many hours of constant research, sourcing and obtaining the highest quality ingredients (both locally and internationally), and constant upgrades (as new research was found), we created the energetic formula. We are proud to introduce you to the Immune Restore Plasma Remedy.
A plasma remedy is an energetic and vibrational remedy that is akin to a homeopathic formula. The body will absorb what it requires at a given time and expel what it does not require. If you would like more information about plasma remedies, please feel free to contact me regarding this amazing technology.
We formulated the remedy to give ultimate holistic support on a physical, mental, emotional and also spiritual level. A complete list of ingredients used to assist with this support can be found in below.
Just a note about vibrations (Based on the work of Dr David Hawkins):
- Energy, Frequency and Vibration sometimes fall into the “woo-woo” category. At the same time, people will understand an EEG, ECG and use Sonars technology. These machines are examples of frequency/electrical energy used in the medical field to measure the physical state of the body. Understanding that we already use similar, well understood technology in the medical industry, assists us in understand the application in other fields as well
- Over years, diseases of all kinds have been measured to have a lower energy. When our energetic field is elevated, it becomes more difficult for disease states to affect us.
- Emotions that lower our vibrations include:
- Fatigue
- Fear
- Nervous tension
- Rage
- Hate
- Behaviours and emotions that higher our vibrations include:
- Generosity: 95 Hz
- Gratitude: 150 Hz
- Compassion: 150 Hz or more
- Love and compassion for all living beings: 150 Hz and more
- Unconditional and universal love: 205 Hz
- Prayer: 120 to 350 Hz
This remedy is made and prepared with love and is proudly endorsed by The African National Healers Association as well. We would love to hear your feedback.